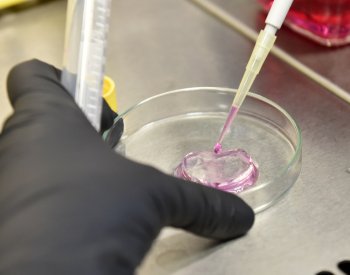
V mražených pelmeních v Písku byla salmonela, prodalo se jich téměř 500 kg

ČNB za první tři čtvrtletí víc než zdvojnásobila objem zlatých rezerv
Praha - Česká národní banka (ČNB) za první tři čtvrtletí letošního roku víc než zdvojnásobila objem svých zlatých rezerv. Ke konci září dosahovaly 806.000 troyských uncí, tedy zhruba 25,1 tuny, vyplývá z údajů o struktuře devizových rezerv, které dnes centrální banka zveřejnila. Hodnota zlatých rezerv na konci čtvrtletí byla 35,363 miliardy korun.